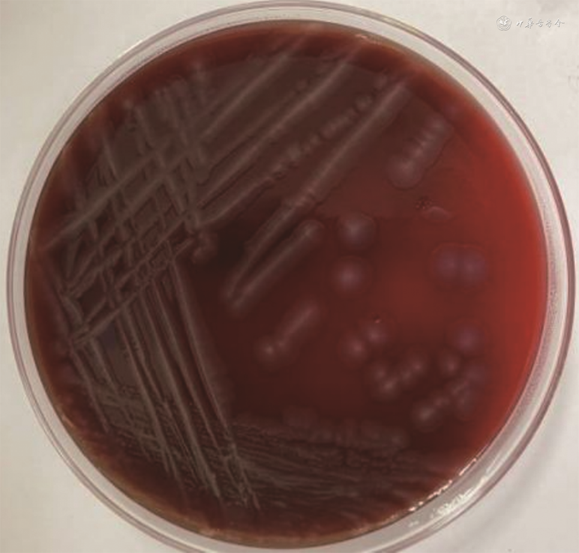
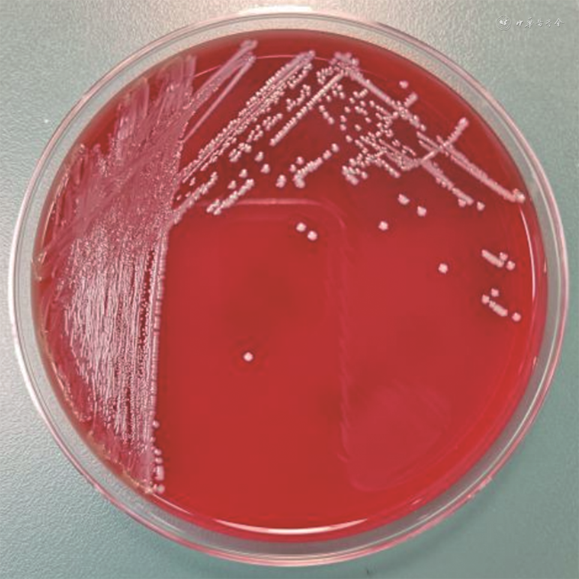

患者中年男性,因“左足踇趾磨损破溃10余天,逐渐出现左足肿胀、发黑,伴嗜睡1 d”于2020年9月5日入住南方医科大学珠江医院。伤口分泌物病原学检查提示为污蝇解壳杆菌、粪肠球菌混合感染。病情发展迅速,经抗感染治疗后患者仍死于感染性休克。污蝇解壳杆菌感染少见,与卫生条件差、慢性开放性伤口相关,需使用基质辅助激光解吸电离飞行时间质谱或16S核糖体RNA基因测序进行菌种鉴定。建议选用头孢菌素类或碳青霉烯类抗生素作为一线用药,血流感染预后不佳。
版权归中华医学会所有。
未经授权,不得转载、摘编本刊文章,不得使用本刊的版式设计。
除非特别声明,本刊刊出的所有文章不代表中华医学会和本刊编委会的观点。
患者男,50岁,因“左足踇趾磨损破溃10余天,逐渐出现左足肿胀、发黑,伴嗜睡1 d”于2020年9月5日入住南方医科大学珠江医院。既往有糖尿病病史,无烟酒嗜好,卫生状况较差。入院时体温36.4 ℃,脉搏114次/min,呼吸28次/min,血压137/80 mmHg(1 mmHg=0.133 kPa)。全身皮肤黄染,左足踇趾及左足内侧坏死,周围可见明显肿胀及渗出,患足皮温低,足背动脉搏动未扪及,可触及捻发感,闻及明显异味。
入院检查:白细胞计数11.7×109/L,中性粒细胞百分数79.7%,降钙素原51.33 μg/L,C反应蛋白230.33 mg/L,炎症指标明显升高。随机血糖26.38 mmol/L,糖化血红蛋白14.6%,乳酸6.4 mmol/L,β羟丁酸1 196 μmol/L,患者血糖长期控制不佳并发酮症酸中毒。血肌酐139.10 mmol/L,总胆红素121.40 μmol/L,直接胆红素97.60 μmol/L,天门冬氨酸氨基转移酶65 IU/L,碱性磷酸酶226 IU/L,肌红蛋白2 567 μg/L,脑钠肽前体11 726 ng/L,心肝肾功能均有不同程度损害。清洗患足后,取深部组织渗出液送检病原学检查,同期送检双套4瓶静脉血培养。
经验性予美罗培南抗感染,辅以清创、纠酸、降糖等对症治疗。患者在入院第2天6:30出现血氧饱和度下降、心率下降,立即行气管插管、肾上腺素静注后一般情况好转,加用替考拉宁联合亚胺培南抗感染治疗。16:00病情进一步恶化,出现高热,酸中毒难以纠正。入院第3天患者心率、血压再次下降,抢救后未见好转,临床死亡。死亡原因:左下肢坏死性筋膜炎、感染性休克,多器官功能损害严重。
病原菌的培养与鉴定:患足伤口渗出液接种至哥伦比亚血琼脂培养基,37 ℃、5% CO2培养箱培养18~24 h后,可见2种菌落形态。分纯后其中一个培养基可见淡灰色、圆形、光滑、边缘整齐的菌落生长,形态见图1,涂片染色后镜下可见呈革兰阴性的短杆状细菌,见图2。另一分纯培养基可见灰白色、湿润、凸起、边缘整齐的菌落生长,形态见图3,涂片染色后镜下可见呈革兰阳性的球菌,见图4。基质辅助激光解吸电离飞行时间质谱(matrix-assisted laser desorption/ionization-time of flight mass spectrometry,MALDI-TOF MS)技术(全自动微生物质谱检测系统Autof ms 1000,安图生物)鉴定报告提示其分别为污蝇解壳杆菌和粪肠球菌。

药物敏感试验采用抗生素浓度梯度法(E-test法,康泰生物科技有限公司)和微量肉汤稀释法进行,最低抑菌浓度结果根据欧洲抗菌药物敏感性试验委员会发布的最新标准[1],应用药代动力学/药效动力学(非物种相关)折点进行评估,提示该株污蝇解壳杆菌对头孢曲松、头孢他啶、美罗培南、亚胺培南、厄他培南、替加环素敏感,对青霉素、氨苄西林、左氧氟沙星、利奈唑胺、磷霉素、妥布霉素耐药。后续将该菌种送至第三方机构行全基因组测序(whole genome sequencing,WGS),证实为污蝇解壳杆菌,并检出红霉素、氯霉素等相关耐药基因(msrE和floR)。同期送检的血培养未见致病菌生长,可能与患者入院前已使用抗生素治疗或血培养检出率不高等原因相关。
污蝇解壳杆菌是一类罕见的致病菌,由匈牙利的Tóth等[2]在2008年从黑须污蝇第3期幼虫的肠道中分离和鉴定,因其分解几丁质的特征而命名为Wohlfahrtiimonas chitiniclastica,即污蝇解壳杆菌。中国在2012年上海浦东国际机场收集的大头金蝇体内也分离出该菌[3],其属革兰阴性菌,短杆状,无运动性,无芽孢,严格需氧[2]。污蝇解壳杆菌对人和动植物都具有致病性,在人类中能导致血流感染、伤口感染、蜂窝织炎、骨髓炎等严重疾病[4],也能引起动物的败血症、心内膜炎、蜂窝织炎等[5, 6, 7],而在一棵欧洲胡杨树的树皮溃疡组织中分离出该菌[8],也证实了其对植物的致病性。本文报告从人体中分离检出污蝇解壳杆菌的临床案例,以提高对该病原微生物的认识及诊疗水平。
污蝇解壳杆菌与黑须污蝇上的另一寄生菌幼虫依格纳季氏菌(Ignatzschineria larvae)具有高度同源性[2]。文献报道几乎所有检出污蝇解壳杆菌的患者都有开放性慢性伤口感染,且近半数存在蛆虫感染皮肤伤口的情况[1,4],污蝇解壳杆菌的感染与苍蝇密切相关。黑须污蝇、丝光绿蝇、大头金蝇、家蝇等作为其有效载体[4],通过苍蝇幼虫在宿主的受损皮肤或黏膜表面传播,侵袭局部组织,而致局部或全身感染。此外,还有一些其他潜在的传播来源,如土壤、鸡肉等[9, 10]。
污蝇解壳杆菌致人类感染的病例报道不多见,主要集中在热带或亚热带地区[11],导致菌血症、脓毒症、皮肤软组织感染或骨髓炎等疾病[1,4]。有3例患者因无明显感染征象[4],推测其为定植菌的可能性大。而已知的感染危险因素主要包括:慢性开放性伤口、血管循环疾病、肥胖、糖尿病等[11],此外经济社会地位低、卫生条件差、抽烟酗酒等社会因素也起到关键作用[1]。本例患者就生活在卫生条件较差的环境,长期血糖控制不佳,末梢血运不良,出现左足踇趾伤口后未及时治疗,病变范围逐渐扩大,并出现全身感染症状。
污蝇解壳杆菌相关感染的临床症状及实验室指标不具有特异性,其诊断主要依靠病原学证据,但由于对该菌的认识不足以及经验性抗菌药物的使用等原因,并不能得到及时确诊。既往报道中,有近1/3的病例在使用Vitek 2系统或API 20 NE进行菌种鉴定时,将污蝇解壳杆菌错误的识别为其他菌种,5例识别为洛菲不动杆菌[4,12, 13],1例识别为放射根瘤菌[4],1例识别为睾丸酮丛毛单胞菌[14],还有1例识别为缺陷短波单胞菌和尿道寡源杆菌[15],最终均由MALDI-TOF MS或16S rRNA基因测序获得病原学证据。Kopf等[16]用MALDI-TOF MS、VITEK 2系统、WGS和16S rRNA基因测序同时对14株污蝇解壳杆菌分离株进行鉴定,结果VITEK 2系统均将其误鉴定为A. lwoffii,其余3种方法则能准确鉴定,这在一定程度上也加大了微生物实验室对该菌的鉴定难度。且污蝇解壳杆菌主要见于混合感染[1],其他微生物的过度生长也会导致其漏检,因此更需要提高对该菌的认识。
由于感染污蝇解壳杆菌非常少见,迄今没有建立标准化的抗感染方案。早期体外药敏试验提示其对多数临床常用抗菌药物敏感,包括青霉素类、碳青霉烯类、头孢菌素类、单环β内酰胺类以及喹诺酮类等[16],可能对磷霉素天然耐药[4,16]。但在近1年的病例报道中,发现其对喹诺酮类抗菌药物出现耐药[17, 18],对头孢菌素类、碳青霉烯类抗菌药物耐药的菌株则暂未见报道。另一值得注意的是,血培养中检出该菌的12例患者中有4例死亡[1],提示污蝇解壳杆菌相关的血流感染较为严重。而对于局部感染,其预后则取决于宿主免疫状况,以及感染的严重程度和护理质量[1,19]。
总之,污蝇解壳杆菌是一种并不多见的致病菌,其感染与慢性开放性伤口及卫生条件差有密切关系,能通过苍蝇幼虫进行传播,导致局部或全身感染。由于污蝇解壳杆菌相关的血流感染较为严重,因此必须快速准确地识别该菌,进行有效抗菌治疗。而基于微量生化反应的Vitek 2系统和API 20 NE并不能正确识别该菌,需使用MALDI-TOF MS或16S rRNA基因测序进行菌种鉴定。对于明确感染的患者,早期文献提出单独使用β内酰胺类或联合喹诺酮类、氨基糖苷类抗菌药物均能取得不错的疗效[4],但随着耐药菌株的相继报道,建议选用头孢菌素类或碳青霉烯类抗菌药物作为一线用药,同时对皮肤伤口的清创也非常重要。由于目前报道的病例数较少,需要更多的流行病学调查以及致病机制研究来认识污蝇解壳杆菌对人类的致病力及可能导致的严重后果。
欧阳津, 李紫岩, 包秉弘, 等. 污蝇解壳杆菌相关的伤口感染1例[J]. 中华检验医学杂志, 2023, 46(11): 1197-1200. DOI: 10.3760/cma.j.cn114452-20230919-00151.
所有作者声明无利益冲突





















